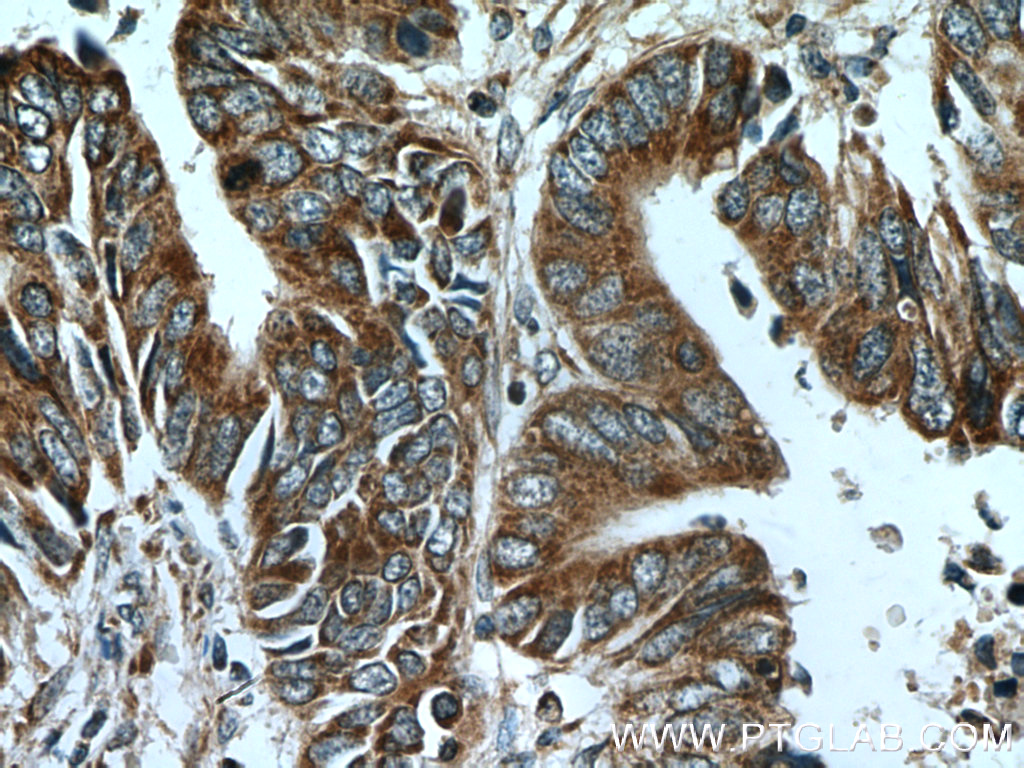

验证数据展示
产品信息
23936-1-AP targets CTGF in WB, IHC, IF, ELISA applications and shows reactivity with human, mouse samples.
| 经测试应用 | ELISA Application Description |
| 文献引用应用 | WB, IHC, IF, ELISA |
| 经测试反应性 | human, mouse |
| 文献引用反应性 | human, mouse, rat, pig, canine, sheep |
| 免疫原 |
CatNo: Ag21008 Product name: Recombinant human CTGF protein Source: e coli.-derived, PET30a Tag: 6*His Domain: 297-349 aa of BC087839 Sequence: RTTTLPVEFKCPDGEVMKKNMMFIKTCACHYNCPGDNDIFESLYYRKMYGDMA 种属同源性预测 |
| 宿主/亚型 | Rabbit / IgG |
| 抗体类别 | Polyclonal |
| 产品类型 | Antibody |
| 全称 | connective tissue growth factor |
| 别名 | IBP 8, Hypertrophic chondrocyte-specific protein 24, HCS24, Cellular communication network factor 2, CCN2 |
| 计算分子量 | 349 aa, 38 kDa |
| 观测分子量 | 38 kDa |
| GenBank蛋白编号 | BC087839 |
| 基因名称 | CTGF |
| Gene ID (NCBI) | 1490 |
| RRID | AB_2736836 |
| 偶联类型 | Unconjugated |
| 形式 | Liquid |
| 纯化方式 | Antigen affinity purification |
| UNIPROT ID | P29279 |
| 储存缓冲液 | PBS with 0.02% sodium azide and 50% glycerol, pH 7.3. |
| 储存条件 | Store at -20°C. Stable for one year after shipment. Aliquoting is unnecessary for -20oC storage. |
背景介绍
CTGF, also known as CCN2 or connective tissue growth factor, is a member of the CCN family of matricellular proteins. CTGF, a cysteine-rich, matrix-associated, heparin-binding protein, is widely expressed in various human tissues and organs. CTGF has important roles in many biological processes, including cell adhesion, migration, proliferation, angiogenesis, skeletal development, and tissue wound repair, and is critically involved in fibrotic disease and several forms of cancers. In western blotting, there are three different forms of CTGF reported: monomeric forms at approximately 36-38 kDa, homodimeric forms at approximately 70 kDa, and lower molecular mass fragment forms.
发表文章
| Species | Application | Title |
|---|---|---|
Redox Biol Endothelial H2S-AMPK dysfunction upregulates the angiocrine factor PAI-1 and contributes to lung fibrosis | ||
EBioMedicine Aspirin targets P4HA2 through inhibiting NF-κB and LMCD1-AS1/let-7g to inhibit tumour growth and collagen deposition in hepatocellular carcinoma. | ||
Cell Death Differ O-GlcNAcylation of MORC2 at threonine 556 by OGT couples TGF-β signaling to breast cancer progression.
| ||
Oncogene Deacetylation of tumor-suppressor MST1 in Hippo pathway induces its degradation through HBXIP-elevated HDAC6 in promotion of breast cancer growth. | ||
Acta Pharmacol Sin KLF4 initiates sustained YAP activation to promote renal fibrosis in mice after ischemia-reperfusion kidney injury. |